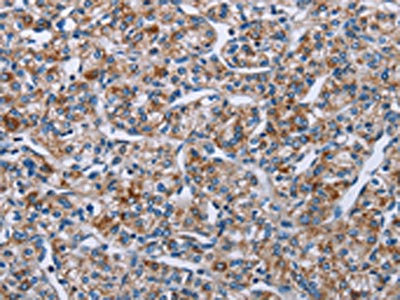

PLCL1 Antibody
-
中文名稱:PLCL1兔多克隆抗體
-
貨號(hào):CSB-PA952795
-
規(guī)格:¥1100
-
圖片:
-
其他:
產(chǎn)品詳情
-
Uniprot No.:
-
基因名:PLCL1
-
別名:Inactive phospholipase C-like protein 1 antibody; Inactive protein 1 antibody; Phospholipase C deleted in lung carcinoma antibody; Phospholipase C epsilon antibody; Phospholipase C like 1 antibody; Phospholipase C related but catalytically inactive protein antibody; Phospholipase C related, but catalytically inactive protein antibody; Phospholipase C-deleted in lung carcinoma antibody; Phospholipase C-related but catalytically inactive protein antibody; Phospholipase C-related catalytically antibody; PLC-L1 antibody; PLCE antibody; PLCL antibody; PLCL1 antibody; PLCL1_HUMAN antibody; PLDL1 antibody; PRIP antibody
-
宿主:Rabbit
-
反應(yīng)種屬:Human
-
免疫原:Synthetic peptide of Human PLCL1
-
免疫原種屬:Homo sapiens (Human)
-
標(biāo)記方式:Non-conjugated
-
抗體亞型:IgG
-
純化方式:Antigen affinity purification
-
濃度:It differs from different batches. Please contact us to confirm it.
-
保存緩沖液:-20°C, pH7.4 PBS, 0.05% NaN3, 40% Glycerol
-
產(chǎn)品提供形式:Liquid
-
應(yīng)用范圍:ELISA,IHC
-
推薦稀釋比:
Application Recommended Dilution ELISA 1:1000-1:2000 IHC 1:25-1:100 -
Protocols:
-
儲(chǔ)存條件:Upon receipt, store at -20°C or -80°C. Avoid repeated freeze.
-
貨期:Basically, we can dispatch the products out in 1-3 working days after receiving your orders. Delivery time maybe differs from different purchasing way or location, please kindly consult your local distributors for specific delivery time.
-
用途:For Research Use Only. Not for use in diagnostic or therapeutic procedures.
相關(guān)產(chǎn)品
靶點(diǎn)詳情
-
功能:Involved in an inositol phospholipid-based intracellular signaling cascade. Shows no PLC activity to phosphatidylinositol 4,5-bisphosphate and phosphatidylinositol. Component in the phospho-dependent endocytosis process of GABA A receptor. Regulates the turnover of receptors and thus contributes to the maintenance of GABA-mediated synaptic inhibition. Its aberrant expression could contribute to the genesis and progression of lung carcinoma. Acts as an inhibitor of PPP1C.
-
基因功能參考文獻(xiàn):
- susceptibility gene for dermatomyositis in Chinese patients with idiopathic inflammatory myopathies PMID: 26603167
- PRIP interacts with the catalytic subunits of PP1 and PP2A and the interactions are regulated by phosphorylation. [review] PMID: 23911386
- effect of DZP on PRIP-1 knockout mice was reduced PMID: 22128345
- In postmenopausal women, our results suggest that the PLCL1 rs7595412 polymorphism has no obvious effect on hip bone size and bone mineral density but may be associated with increased proportion of vertebral fracture and increased levels of osteocalcin PMID: 20030815
- PRIP-1 plays an important role in type A receptor signaling for gamma-aminobutyric acid in the brain PMID: 16952428
- PLCL1 is a novel gene associated with variation in hip bone size, which has a role in the pathogenesis of hip fractures PMID: 18776929
顯示更多
收起更多
-
亞細(xì)胞定位:Cytoplasm.
-
組織特異性:Expressed in a variety of fetal and adult organs including brain, lung and kidney. Its expression was greatly reduced in small and non-small cell lung carcinoma. Isoform 1 is predominantly expressed in brain.
-
數(shù)據(jù)庫(kù)鏈接:
Most popular with customers
-
-
YWHAB Recombinant Monoclonal Antibody
Applications: ELISA, WB, IHC, IF, FC
Species Reactivity: Human, Mouse, Rat
-
Phospho-YAP1 (S127) Recombinant Monoclonal Antibody
Applications: ELISA, WB, IHC
Species Reactivity: Human
-
-
-
-
-